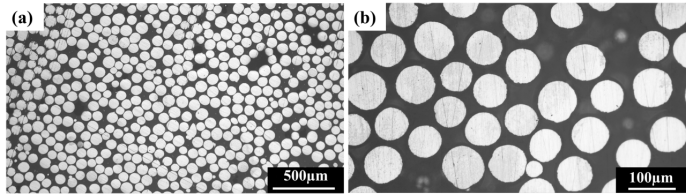

一.🌕|纯铜(Cu):增材制造导热零部件的优选材料
纯铜兼具优良导电、导热与延展性,纯铜凭借高导电性、导热性及良好延展性,广泛应用于电气电子、导热散热、机械制造等领域,用于制作电线电缆、散热器件、换热器及精密零件等。是增材制造高导热构件的核心候选材料,曾因激光反射率高、熔池不稳定等问题限制应用。当前绿/蓝光打印工艺、材料改性等技术突破,大幅提升其成型致密度与热导率稳定性,已推动其在电子散热、航空航天等高端领域落地,有效解决传统制造难以攻克的复杂构件加工难题,正逐步打破行业瓶颈。
二.🌀|Cu粉末制备工艺:从铸棒到粉末的高纯制备
等离子旋转电极雾化制Cu粉(PREP),是通过转弧等离子热源加热高速旋转的Cu铸棒,形成液态金属薄膜,薄膜被离心力破碎成细小液滴,并快速凝固形成粉末。
1.粉末化学成分(wt%)
|
元素 |
标准 |
检测结果 |
元素 |
标准 |
检测结果 |
|
Cu+Ag |
≥99.9 |
99.931 |
Pb |
≤0.005 |
0.000047 |
|
Bi |
≤0.001 |
0.000016 |
Sn |
≤0.05 |
0.000022 |
|
Sb |
≤0.002 |
0.000048 |
S |
≤0.005 |
0.00046 |
|
As |
≤0.002 |
0.00002 |
O |
≤0.01 |
0.0066 |
|
Fe |
≤0.005 |
0.000055 |
N |
≤0.005 |
0.0001 |
-
PREP制得Cu粉末氧氮含量低,氧含量≤70ppm,氮含量≤2ppm。
2.53-106μm粉末特性:

PREP制备Cu粉末SEM图像
-
PREP制Cu粉末粉末表面光滑、球形度好、少卫星粉及空心粉、流动性好、粒度分布窄。
|
粒度分布D10(μm) |
62.59 |
球形度 |
97.95% |
|
粒度分布D50(μm) |
94.52 |
空心粉率 |
0.036% |
|
粒度分布D90(μm) |
142.6 |
|
|
-
PREP制Cu粉末 粒度分布窄(D10为62.59μm、D50为94.52μm、D90为142.6μm),球形度高(97.95%),及空心粉率低(0.036%)。
PREP制备的Cu粉末颗粒金相截面图(a)(b)
-
PREP制备的Cu粉末颗粒呈现非常规则的圆形截面,颗粒内部无明显孔洞,几乎没有空心粉。
三.🔥|应用领域:纯铜 AM赋能散热

电子散热器件 火箭发动机 感应线圈
纯铜粉末凭借其极致导热性与增材制造精密成型优势,正成为高附加值制造领域的核心材料。从电子设备散热器件到航空航天部件,其实际应用中已实现复杂结构一体化成型与性能升级。未来,随着绿 / 蓝光打印技术的规模化应用与低氧粉末制备工艺的优化,纯铜粉末将进一步深耕散热与消费电子高附加值赛道,助力产品实现轻量化、高效能与低成本的协同突破。
五.💎|中科布拉菲材料技术(东莞)有限公司
中科布拉菲以自主研发的PREP制粉装备和技术、深耕金属粉末材料领域,包括高温合金粉末、模具钢粉末、钛合金粉末等,为航空航天、能源、医疗、模具等行业提供高性能3D打印材料。
我们相信,
真正的创新,不止于材料,更在于对制造边界的重新定义。
END

